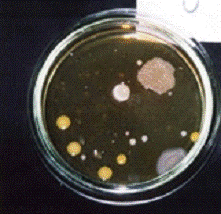
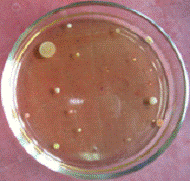

Материал: Исследование экологической среды жилого дома
Исследование экологической среды жилого дома
Министерство образования и науки РФ
Федеральное государственное автономное образовательное учреждение высшего образования
«КАЗАНСКИЙ (ПРИВОЛЖСКИЙ) ФЕДЕРАЛЬНЫЙ УНИВЕРСИТЕТ»
ИНСТИТУТ ФУНДАМЕНТАЛЬНОЙ МЕДИЦИНЫ И БИОЛОГИИ
КАФЕДРА МИКРОБИОЛОГИИ
ПРОЕКТ
ИССЛЕДОВАНИЕ ЭКОЛОГИЧЕСКОЙ СРЕДЫ
ЖИЛОГО ДОМА
Введение
Нам часто кажется, что загрязнения окружающей среды подкарауливают нас лишь на улице, и поэтому на экологию наших домов и квартир мы обращаем мало внимания. Однако жилые помещения это не только укрытие от неблагоприятных условий окружающего мира, но и мощный фактор, воздействующий на человека и в значительной степени определяющий состояние его здоровья. На качество среды в жилище влияют: наружный воздух; продукты неполного сгорания газа; вещества, возникающие в процессе приготовления пищи; вещества, выделяемые мебелью, книгами, одеждой и т. д.; продукты табакокурения; бытовая химия и средства гигиены; комнатные растения; санитарные нормы проживания (количество людей и домашних животных); электромагнитное загрязнение. Поэтому исследование состояния жилища с экологической точки зрения, решение проблемы создания здоровой среды обитания для человека в настоящее время являются очень актуальными.
Цель данного проекта - исследовать экологическую среду жилого дома и предложить меры по созданию экологически безопасной для человека среды обитания.
Задачи:
1. Провести анализ микрофлоры воздуха в доме;
. Измерить и оценить параметры микроклимата в помещении;
. Определить источники электромагнитного излучения в доме;
. Изучить состав различных средств бытовой химии;
. Количественно оценить уровень теплового излучения в помещении;
. Выявить в доме различные газообразные загрязнители.
1. Обзор литературы
.1 Микрофлора воздуха
Состав микрофлоры воздуха разнообразен и значительно изменяется в зависимости от метеорологических условий, расстояния от поверхности земли, а также зависит от самого населенного пункта. Наибольшее количество микробов содержит воздух промышленных городов, наименьшее- воздух лесов, гор. В воздухе закрытых помещений микробов значительно больше, особенно при скоплении людей. В открытом воздухе количество микроорганизмов зимой меньше, чем летом, а в воздухе закрытых помещений соотношение обратное.
В воздухе могут находиться споры различных бактерий и грибов. Постоянными обитателями воздушной среды являются бактерии родов Micrococcus, Bacillus и Sarcina, а также плесневые грибы и дрожжи. Помимо всего, в воздухе могут находиться патогенные микроорганизмы. Они попадают в воздух от людей - больных или бактерионосителей, а также от животных, выделяясь главным образом через дыхательные пути. Патогенные микробы могут попасть в воздух с пылью от загрязненных предметов (одежда, одеяла и др.) либо из инфицированной почвы. Споры многих фитопатогенных грибов рассеиваются с пораженных растений и разносятся ветром.
При санитарно-гигиенической оценке воздуха используют 2 метода:
· Аспирационный - заключается в принудительном оседании микроорганизмов из воздуха на поверхность плотных питательных сред; для этого необходим специальный прибор, снабженный вентилятором, который засасывает воздух;
· Седиментационный - основан на самопроизвольном оседании пылинок и капель на поверхность плотной питательной среды.
После этого определяют общее количество микроорганизмов, находящихся в 1м3
воздуха. Критерии для оценки воздуха жилых помещений изображены в следующей
таблице:
Таблица 1
Оценка воздуха
Летний режим
Зимний режим
Общее количество микроорганизмов/м3
Чистый
1500
4500
Грязный
2500
.2 Микроклимат помещения и его влияние на здоровье человека
Внутренний баланс организма человека во многом зависит
от внешних условий. Микроклимат помещения, в котором человек находится долго,
играет существенную роль в формировании иммунитета, работоспособности,
возможности комфортно отдохнуть и расслабиться. Чем дольше мы пребываем в том
или ином месте, тем сильнее оно способно вмешаться в работу нашего организма.
Микроклимат любых помещений характеризуется
температурой воздуха, его влажностью и скоростью движения. Необходимо
рассмотреть каждый фактор формирования микроклимата отдельно.
Температура помещения - самый важный показатель
комфортности. От температуры напрямую зависит и влажность воздуха. Низкие
температуры провоцируют отдачу тепла организмом человека, тем самым снижая его
защитные функции. Очень высокая температура в помещении (более 27 градусов)
влечёт за собой не меньшие проблемы. Борясь с жарой, организм выводит соль из
организма. Такая ситуация также чревата снижением иммунитета, нарушением
водно-солевого баланса, который регулирует работу многих систем в организме.
Кроме перечисленного, температура в помещении влияет на работоспособность
человека. Ни жара, ни холод не позволят комфортно работать и отдыхнуть
организму.
Влажность воздуха - это фактор, который в большой
степени зависит от температуры. Чем выше температура, тем суше будет воздух.
Сухой воздух, в свою очередь, сушит слизистые поверхности человека и пагубно
влияет на лёгкие. Здоровый человек, попав в помещение с сухим воздухом,
почувствует дискомфорт уже через 10-15 минут. Если же человек уже простужен, он
начнёт кашлять.
В меру влажный воздух (40-60%) создаст комфортные
условия для работы и отдыха. В зимний период он способствует укреплению
иммунитета, так как не позволяет пересыхать слизистой и становиться уязвимой
для вирусов. В летний период при комфортной влажности легче переносить жару,
поддерживать здоровое состояние кожи и пр.
Скорость движения воздуха - фактор микроклимата, на
который многие вообще не обращают внимания, хотя он не менее важен. Дело в том,
что в зависимости (опять же) от температуры воздуха скорость его движения
влияет на организм по-разному. Например, при температуре до 33-35 градусов
скорость в 0,15 м/с комфортна, так как при этом воздух оказывает освежающий
эффект. Если температура выше 35 градусов, то эффект будет обратным.
1.3 Электромагнитное излучение и его воздействие на человека
Электромагнитное поле - особая форма материи. Посредством
электромагнитного поля осуществляется взаимодействие между заряжёнными
частицами. Тело человека имеет свое электромагнитное поле как любой организм на
земле, благодаря которому все клетки организма гармонично работают.
Электромагнитные излучения человека еще называют биополем (видимая его часть -
аура). Такое поле является основной защитной оболочкой нашего организма от
любого негативного влияния. Разрушая ее, органы и системы нашего организма
становятся легкой добычей для любых болезнетворных факторов. Прежде всего,
уязвимыми являются нервная, иммунная, сердечнососудистая, эндокринная и половая
системы.
Если на наше электромагнитное поле начинают действовать другие источники
излучения, гораздо более мощные, чем излучение нашего тела, то в организме
начинается хаос. Это и приводит к кардинальному ухудшению здоровья. Слабые же
электромагнитные поля (ЭМП) мощностью сотые и даже тысячные доли Ватт высокой
частоты для человека опасны тем, что интенсивность таких полей совпадает с
интенсивностью излучений организма человека при обычном функционировании всех
систем и органов в его теле. В результате этого взаимодействия собственное поле
человека искажается, провоцируя развитие различных заболеваний, преимущественно
в наиболее ослабленных звеньях организма.
Источниками электромагнитного излучения могут быть:
· Геопатогенные
зоны
· Социопатогенное
излучение: влияние людей друг на друга
<#"818005.files/image001.gif">
где tи - истинная температура;Б- показания термометра с посеребренным
резервуаром;Т- показания термометра с зачерненным резервуаром;- константа
данного прибора (по паспорту), обычно - в пределах 0.10 - 0.12.
Температуру поверхностей приборов измерили аналогично измерению
температуры воздуха.
. Возможные источники выделения формальдегида определяли визуально,
основываясь на обзоре литературы и собственных знаниях. После этого определили
некоторые меры защиты от опасных испарений формальдегида и родона.
3. Результаты исследования
.1 Анализ микрофлоры воздуха
Рассматривая визуально колонии микроорганизмов, мы обнаружили, что они
имеют различную форму, структуру, цвет и размер. На некоторых чашках Петри
выросли также грибы (см.Рис.1,прихожая).
Рисунок 1 - анализ микрофлоры воздуха в различных помещениях жилого дома
Было подсчитано количество отдельных колоний в каждой чашке, а также
подсчитано общее количество микроорганизмов, содержащихся в 1 м3
воздуха, в каждой отдельной комнате. Результаты приведены в следующей таблице:
Таблица 3.1
Прихожая
Кухня
Гостиная
Спальня
Норма
Кол-во мко/м3
4561
1388
3182 Чистый - до 4500 Загрязненный - 7000 и более
Загрязненный воздух был отмечен лишь в прихожей, в остальных же
помещениях воздух в пределах нормы. Для того, чтобы воздух прихожей оставался
чистым, необходимо как можно чаще делать влажную уборку и проветривать
помещение.
Рисунок 2 - Анализ пыли с различных источников
Максимальное количество пыли оседает в жилых
помещениях на поверхности мебели, а также в труднодоступных для уборки местах.
Рассмотрев частицы пыли под микроскопом, мы обнаружили, что они неоднородны по
составу и размеру, серого цвета, соединены между собой ворсинками. Пыль
неоднородна и по структуре: книжная пыль - серого цвета, состоит из мельчайших
частиц (мелкодисперсная), древесная пыль - более крупная. Пыль, собранная с
ковровых дорожек, содержит более крупные частицы, которые соединены ворсинками,
может включать шерсть животных.
Частицы пыли могут глубоко проникать в легочную
систему и при длительном контакте вызывать хронические воспалительные
заболевания дыхательных путей (трахеиты, бронхиты, бронхиальную астму) и легких
(бронхопневмонии), поэтом необходимо как можно чаще проводить влажную уборку в
доме, а также проветривать помещения.
Состояние микроклимата в комнатах квартиры мы
исследовали с помощью термометра и психрометрического гигрометра. Приборы
устанавливали в гостиной. Результаты приведены в следующей таблице:
Таблица 3.2
Период года
Температура, °С
Относительная влажность, %
Полученный результат
Санитарно-гигиеническая норма
Полученный результат
Санитарно-гигиеническая норма
Холодный и переходный
26
18-22
59
65
Показатели температуры находились выше нормы, поэтому и влажность воздуха
была ниже положенного. Отклонения в обоих параметрах не столь значительны.
Мы провели исследование в доме и обнаружили, что
электромагнитное излучение производят следующие приборы: СВЧ-печь, компьютер (2
шт.), телевизор (3 шт.), холодильник, сотовые телефоны (3 штуки), электрический
водонагреватель, стиральная машина.
Чтобы защитить себя от воздействия электромагнитных полей, следует
выполнять не сложные правила по технике безопасности. Основное, что все должны
знать, прежде чем поставить электроприбор в определённое место, это то, что
нужно бояться не величины магнитного поля, а расстояния между вами и прибором
во время его работы. Включив электроплиту или микроволновку, отойдите от них
подальше, дожидаясь звукового сигнала, который и сообщит вам об окончании
работы электроприбора. Холодильник включается ненадолго и выключается
автоматически. Его следует ставить в углу кухни, на расстоянии от людей не
ближе чем 1,2 м. Любителям смотреть телевизор подолгу, рекомендуется сидеть от
него на расстоянии не менее 1,5 м. Компьютер нужно располагать так, что бы
задняя и боковые панели системного блока и монитора не были направлены вглубь
помещения. Лучшее их положение - в углу, выходящем на улицу. Также, следует
знать, что электромагнитное излучение от боковых стенок сильнее, чем от экрана.
На случай, если у кого-то ещё вдруг остались мониторы с электронно-лучевыми
трубками, напомню, что излучение от них значительно больше, чем от
жидкокристаллических мониторов. Минимальное расстояние от вас до экрана и
компьютера, должно быть 50 см. Ноутбук при работе находится в непосредственной
близости с вами, поэтому, вред от электромагнитных волн максимален. Снизить его
поможет, только сокращение работы за ноутбуком, делайте перерывы в работе,
постарайтесь располагать ноутбук на столе, что бы ваш контакт с ним сводился к
минимуму. Радио и мобильные телефоны также излучают электромагнитные волны.
3.4 Изучение состава различных средств бытовой химии
В ходе исследования нами были изучены составы различных средств бытовой
химии с целью установления наличия в них химических веществ, опасных для
здоровья человека.
Данные полученные нами в ходе исследования приведены в таблице:
Таблица 3.3
ВЕЩЕСТВА
Средства бытовой химии, содержащие данные вещества
ПАВ анионные
Стиральные порошки: Миф, Ушастый нянь, Биолан, Ласка, Sarma, Deni, Dreft,
Vanish, Tide, Mr.Proper, Losk, Dosia,
Ariel, Persil. Средства для мытья посуды:
Биолан, ПемоЛюкс, Капля, Fairy,
Pril
ПАВ катионные
Стиральные порошки: Tide, Mr.Proper Средства для мытья посуды:
Биолан, Капля, Pril.
ПАВ неионогенные
Стиральные порошки: Миф, Ушастый нянь, Биолан, Ласка,
Аистёнок, Sarma, Deni, Dreft,
Vanish, Tide, Mr.Proper, Losk, Dosia,
Ariel, Persil. Средства для мытья посуды:
Биолан, Fairy .
Фосфаты
Стиральные порошки: Миф, Аистёнок, Ушастый нянь, Биолан,
Ласка, Sarma, Deni, Dreft,
Tide, Mr.Proper, Losk, Ariel, Persil.
Sls (Sles) Лаурил (Лаурет) сульфат натрия
Используются как эмульгаторы и пенообразующие вещества в
очищающих лосьонах для кожи лица, в шампунях, лосьонах для тела и для ванн, в
мыле. Например, Fruktis, Timotei, Head and Shoulders, Garnier, Shauma, Чистая линия, Красная линия, Сто
рецептов красоты.
Сульфаты
Стиральные порошки: Ушастый нянь, Sarma
Карбонаты
Стиральные порошки: Sarma
Sodium Chloride
Придаёт вязкость косметическим средствам. Например, Fruktis, Timotei, Head and Shoulders, Чистая линия.
Alcohol
Содержится в косметических средствах, например, Чистая
линия.
3.5 Количественная оценка уровня теплового излучения в помещении
Результаты измерения уровня теплового излучения в доме представлены на
следующей таблице:
Температура воздуха 20-28
Температура поверхностей 12-29
.6 Определение различных газообразных загрязнителей
Визуально определили возможные источники формальдегида. Это - новые ковры
и занавески, обивка мебели и утеплители (пенопласт).
Вентиляция и низкая влажность естественно понижает содержание
формальдегида в воздухе помещений. Также необходимо оградить себя от
материалов, которые выделяют формальдегид, важно изучать состав изделия перед
его покупкой.
Через трещины в основании дома и в подвальных помещениях в дом из грунта
могут также попадать различные радиоактивные и другие типы загрязнителей.
Для защиты жилых помещений дома от радона устраивают два рубежа обороны:
. Выполняют газоизоляцию ограждающих строительных конструкций,
которая препятствует проникновению газа из грунта в помещения.
. Предусматривают вентиляцию пространства между грунтом и
защищаемым помещением. Вентиляция снижает концентрацию вредного газа на границе
грунта и помещения, до того, как он сможет проникнуть в помещения дома.
1. Количество микроорганизмов в различных
комнатах дома соответствует норме, кроме прихожей; максимальное количество пыли
оседает в помещении на поверхности мебели, а также в труднодоступных для уборки
местах.
2. По показателям температуры и относительной
влажности воздуха полученные результаты имеют незначительные отклонения от
нормы.
. В доме имеет место электромагнитное
излучение, причем в достаточно больших количествах.
. Нами был изучен химический состав средств
бытовой химии с целью выявления веществ, содержащихся в них. Многие средства
бытовой химии, широко используемые в ежедневном обиходе, содержат вредные и
опасные для здоровья и жизни человека химические вещества.
. В ходе исследования оценили количественно
тепловое излучение в жилом помещении - все показатели соответствовали нормам;
6. В ходе исследования было выяснено, что максимальные значения
концентрация формальдегида, достигает, как правило, при теплых влажных
условиях, особенно в закрытых непроветриваемых помещениях. Таким образом, для
снижения концентрации формальдегида необходимо поддерживать оптимальную
температуру (не более 27°С) и влажность (не более 60%) в помещении. Вентиляция
и низкая влажность естественно понижает содержание формальдегида в воздухе
помещений. Также необходимо оградить себя от материалов, которые выделяют
формальдегид, важно изучать состав изделия перед его покупкой.
Список использованных источников
1. Громова В.А. Руководство для самостоятельной работы
студентов по санитарной микробиологии воды, почвы, лечебно-профилактических
организаций / В.А. Громова, Ю.В. Хахарова// Кемерово. - 2010. - 90 с. . Пистун И.П. Лекции по охране труда: Учебное пособие
\ И.П. Пистун / / Изд. «Университетская книга». - 1999.
. Степановских А.С. Экология (учебник):
 ПРИХОЖАЯ
ПРИХОЖАЯ
КУХНЯ
КУХНЯ
 ГОСТИНАЯ
ГОСТИНАЯ
СПАЛЬНЯ
СПАЛЬНЯ
 книжная пыль
книжная пыль
 пыль с включениями шерсти животных
пыль с включениями шерсти животных
 древесная пыль
древесная пыль
 пыль с ковровых дорожек
пыль с ковровых дорожек
.2 Измерение и оценка параметров
микроклимата квартиры
3.3 Определение источников
электромагнитного излучения в доме
Выводы